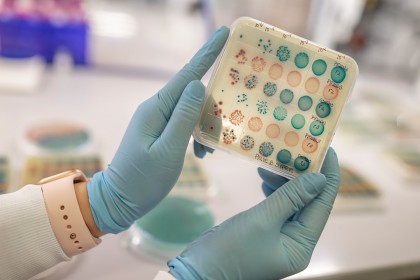

Un nou biomarker al infecțiilor urinare recurente, identificat de cercetători
©
Autor: Teodorescu Mihai
Pentru studiu, cercetătorii au testat 75 de femei, clasificate în trei grupuri, în funcție de istoricul medical cu privire la infecțiile urinare recurente ale tractului urinar. Astfel, în primul grup au fost incluse femei fără antecedente de UTI, în al doilea grup femei care au avut infecții urinare recurente și sufereau de o infecție la momentul testării, în timp ce, în ultimul grup au fost incluse femeile care au avut infecții urinare în trecut, dar care nu aveau o infecție la momentul testării.
Cercetătorii au descoperit că femeile care au avut antecedente de infecții urinare recurente, dar care la momentul testării nu sufereau de o infecție urinară, au avut un microbiom bogat în microorganisme patogene, care ar fi putut declanșa boli ale tractului urinar. În cazul celor care urmau terapii cu estrogen, nu a existat o astfel de acumulare de bacterii patogene. Autorii sunt de părere că noile informații pot ghida dezvoltarea de noi instrumente de screening și prevenire a bolii.
Infecțiile tractului urinar sunt printre cele mai comune infecții bacteriene întâlnite în rândul adulților, cu o prevalență mai ridicată la femei. Statisticile arată că aproximativ jumătate dintre femei se confruntă cu infecții recurente ale tractului urinar pe parcursul vieții.
sursa: Science Daily
foto: The University of Texas at Dallas
Data actualizare: 15-12-2022 | creare: 15-12-2022 | Vizite: 638
Bibliografie
Who is more prone to recurrent UTIs? Bladder bacteria may be key, link: https://www.sciencedaily.com/releases/2022/12/221212140548.htm ©
Copyright ROmedic: Articolul se află sub protecția drepturilor de autor. Reproducerea, chiar și parțială, este interzisă!
Alte articole din aceeași secțiune:
- Analizele de sânge de rutină ar putea accelera diagnosticarea cancerului pentru pacienții cu dureri de stomac sau balonare
- Tratament cu plasmă la presiune atmosferică joasă pentru vindecarea fracturilor greu vindecabile
- Mecanismul de funcționare a unui medicament utilizat împotriva unei boli tropicale comune, descris de cercetători
- Un nou studiu identifică teste de sânge eficiente pentru diagnosticul și monitorizarea SLA
Din Ghidul de sănătate v-ar putea interesa și:
Forumul ROmedic - întrebări și răspunsuri medicale:
Pe forum găsiți peste 500.000 de întrebări și răspunsuri despre boli sau alte subiecte medicale. Aveți o întrebare? Primiți răspunsuri gratuite de la medici.- Infecție urinară frecventă
- Infectie urinara cu Klebsiella
- Infectie urinara recidivanta cu pseudomonas aeruginosa la 92 ani
- Pot fi insarcinata daca nu am simțit ejacularea partenerului prin prezervativ?
- Infectii recurente de 4 ani, ajutor
- Infecții urinare repetate cu durere de ovar in partea dreapta
- Sarcina si infecția urinară. Prezintă un risc? Se poate trata?
- Cistita cu Monural
- Infectii urinare